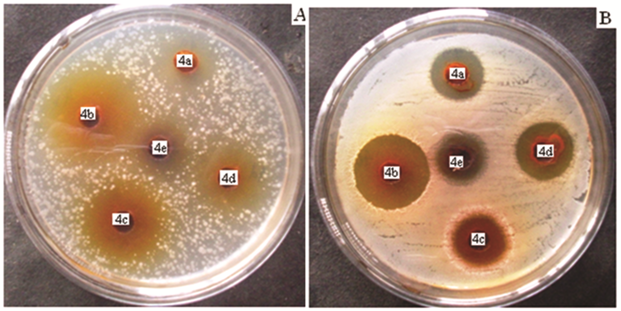

Int J Pharm Pharm Sci, Vol 7, Issue 7, 427-433Original Article
ANTIMICROBIAL AND ANTIOXIDANT ACTIVITIES OF SOME NEWLY SYNTHESIZED BENZENE-1, 3-DIOL CONGENERS AND THEIR CHARACTERIZATION
SUDHIR KUMAR PAIDESETTY, SUSANTA KUMAR ROUT, JYOTIRMAYA SAHOO*
Department of Pharmaceutical Chemistry, School of Pharmaceutical Sciences, Siksha‘O’Anusandhan University, Bhubaneswar, Odisha, India, 751003
Email: jjyotisahoo@rediffmail.com
Received: 22 Mar 2015 Revised and Accepted: 30 May 2015
ABSTRACT
Objective: The aim of the research work is to synthesize some of novel Benzene-1, 3-diol analogues by incorporation of various aryl and hetero arylazo moieties. The newly synthesized Benzene-1, 3-diol congeners were evaluated to study their in vitro antimicrobial and antioxidant activities.
Methods: This part of the research work includes the synthesis of a series of Benzene-1, 3-diol analogues by coupling of Benzene-1, 3-diol with different di azotized aryl and hetero aryl amines. Their structures and physical characteristics were confirmed by different modern analytical techniques viz. FT/IR, 1H NMR, UV-vis spectroscopy, LC-MS, DSC and elemental analysis. The in vitro antimicrobial activity of the synthesized compounds were performed by cup and plate method against different gram positive and gram negative bacterial and fungal strains. The radical scavenging activity of the Benzene-1, 3-diol analogues was measured by DPPH model.
Results: The results of antimicrobial activity of Benzene-1, 3-diol analogues were statistically interpreted. The newly synthesized compounds of Benzene-1, 3-diol substituted with antipyrinyl and isoxazolyl nucleus showed significant antimicrobial activities when compared with standard drugs. The Benzene-1, 3-diol analogues also exhibited effective antioxidant activity.
Conclusion: The research work concluded that the newly synthesized Benzene-1, 3-diol analogues posses significant antimicrobial and potential antioxidant activity.
Keywords: Benzene-1, 3-diol, Antimicrobial, Antioxidant, Spectral analysis.
INTRODUCTION
Microorganisms are resistant to conventional antimicrobial treatment as they have acquired resistance genes in their DNA and can also transfer it to the sensitive microbes during the course of their mutation. Therefore, the drug resistance problem needs continuous discovery of novel antimicrobial agents by exploiting the existing molecules with different chemical entities. Sixty percent of the total number of dyes belongs to azo groups [1]. Though azo dyes exhibit a broad range of colours, yellow and red colours are mostly common. Extended conjugation of aromatic or hetero aromatic rings through diazotization attributed different colours [2]. Absorption of light in the visible range, due to extended conjugation in azo dyes makes most of the azo analogues chromatic. Azo dyes are better stable in a wide range of PH and temperature than natural dyes. The colouring property of those dyes even lasts longer even when often exposed to light and oxygen [2]. Azo dyes are more accepted in the food processing units due to their low toxicity, no hyperactivity effect and less allergic reactions (ex-tartrazine, azorubin etc.) [3]. Not only in the food sector but also in textile and non-textile sectors like reprography, dye sensitizing solar cells and metalochromic indicators, etc [4], azo dyes have their importance. The-N=N-linkage is the most sensitive part of the azo dyes that can undergo enzymatic breakdown by azo-reductase (intestinal bacteria origin enzyme) and split into two different molecules [5]. For various applications, phenolics are considered as binding resins or matrix resins. Resorcinol is a good phenolic candidate with exceptional clinical activity [6]. Literature support reveals that 4-n-butyl resorcinol is used as skin creams and lotions with good antimicrobial and bleaching action whereas 2-alkyl resorcinol is noted to have skin de-pigmentation properties [7]. A new class of azo dyes from resorcinol and other coupling agents exhibit significant antioxidant and antimicrobial activities [8]. Incorporation of suitable heterocyclic moieties enhances the biological potency of azo-linked compounds [9]. Azo compounds are biologically important for their well known therapeutic properties such as antineoplastic [10], anti-inflammatory [11], antiseptic [12], antimicrobial [13], antioxidant [14] and antidiabetics [15]. Bacterial resistance to the modern antibiotics has become a clinical crisis. A survey report claimed that Cloxacillin is highly resistant to gram positive bacteria like Staphylococcus aureus, Streptococcus species and Enterococcus species [16]. Recent survey revealed that antibiotic resistance to urinary tract infections was highest in the Southeast, specifically in the East Central and South Atlantic states. Urinary tract infections are more common among women. Most women suffered from Urinary tract infections at least once in their lives. Without proper treatment UTIs may lead to blood stream infections and may become life threatening. The causative pathogens for UTIs are Escherichia coli, Pseudomonas aeruginosa, Klebsiella pneumonia etc. In view of the above mentioned facts, we dedicate our sincere effort to synthesize a number of azo dyes using resorcinol by inserting various aryl and hetero aryl azo moieties and investigate their structural environment and various biological applications like antimicrobial and antioxidant activities. The synthesized molecules are subjected to different electronic environments, to study their solvatochromic behavior.
MATERIALS AND METHODS
General
All the chemicals used in the present studies were of synthetic grade and sourced from E. Merck (Mumbai, India) and HIMEDIA (Nashik, India). Spectral characterizations of the synthesized compounds were interpreted by FT/IR (JASCO FT/IR 4100 Spectrophotometer using KBr disc), 1H NMR (Bruker 1H NMR 300 MHz) using TMS as an internal standard, LC-MS (Shimadzu-Mass spectrometer) and Elemental Analysis were carried out by using Perkin Elmer-2400 CHNO/S analyzer system. Differential scanning calorimetry (METTLER TOLEDO STARe system at a heating rate of 10 °C min-1, temperature range 30-350 °C using aluminium cans calibrated with indium). Solvent behavior of the compounds was studied by UV-Vis spectrophotometer (JASCO V-630 Spectrophotometer). The synthesized compounds were evaluated for their in vitro antimicrobial activity against different bacterial and fungal strains by cup and plate method and the antioxidant activity by DPPH model.
General procedure for synthesis of 4-aryl/hetero aryl azo Benzene-1, 3-diol analogues [17]
An ice-cold solution of sodium nitrite (0.207g, 3 mmol) was added drop wise to the solution of six different individual substituted aryl and hetero aryl amines (3 mmol) with conc. hydrochloric acid (8-9 mmol) and water (5 ml) on an ice bath. The temperature of the reaction was maintained at a range between 0-5 °C. When addition was completed, the solution was kept for 15 min with occasional stirring to complete the diazotization. Then it was poured into an ice-cold solution of Benzene-1, 3-diol (0.543g, 3 mmol) in 20 ml of 10% sodium hydroxide solution. Then the resultant mixture was stirred and kept on an ice bath for 30 min at a temperature between 0-5 °C. The pH was maintained between 5-6. The obtained products were filtered and washed with cold distilled water. The final product was dried and re-crystallized by ethanol.

Scheme 1
4-((4-bromo-3-methylphenyl) diazenyl) benzene-1, 3-diol (4a)
The product was prepared by diazotized 4-bromo-3-methyl aniline coupled with resorcinol; Dark red color powder; Yield 85%; Rf; 0.8, mp ( °C); 183-185, UV-vis (λ max, ethanol): 392 nm; IR (KBr, γ, cm-1): 3450 (O-Hstr), 1615 (C=C str. resorcinol), 1476 (-N=N-),1241 (O-H bend), 1027 (C-O str.), 811 (1,3,4-CHAr); 1H NMR (DMSO-d6, δ ppm, 300 MHz): 10.69 (s, 1H, OH), 2.46 (s, 3H, CH3), 7.14 (s, 1H, resorcinol H-2), 7.58 (d, 1H, resorcinol, H-5), 6.53 (d, 1H, resorcinol H-6), 7.68 (s, 1H, ArH-2'), 7.60 (d, 1H, ArH-5'), 7.62 (d, 1H, ArH-6'); LC-MS (ret. time, % area); 2.659, 60.47; m/z; 307.2 (M+1); Analysis for C13H11BrN2O2: calcd % C, 50.84; H, 3.61; N, 9.12; Found %: C, 50.80; H, 3.62; N, 9.15.
4-((4-hydroxyphenyl) diazenyl) benzene-1, 3-diol (4b)
The product was prepared by diazotized 4-amino phenol coupled with resorcinol; Dark red color powder; Yield 90%; Rf; 0.8; mp ( °C); 197-200, UV-vis (λ max, ethanol):386 nm; IR (KBr, γ, cm-1): 3443, 3201 (O-Hstr), 1603 (C=C str. resorcinol), 1506 (-N=N-),1254 (O-H bend), 1118 (C-O str.), 833 (1,4-CHAr); 1H NMR (DMSO-d6, δ ppm, 300 MHz): 10.25 (s, 1H, OH), 6.69 (s, 1H, resorcinol H-2), 7.65 (d, 1H, resorcinol H-5), 6.63 (d, 1H, resorcinol H-6), 7.10-7.83 (dd, 4H, ArH,); LC-MS (ret. time, % area); 1.855, 98.46; m/z; 231.1 (M+1); Analysis for C12H10N2O3: calcd % C, 62.07; H, 4.38; N, 12.17; Found %: C, 62.09; H, 4.36; N, 12.15.
4-((2, 4-dihydroxyphenyl) diazenyl) benzoic acid (4c)
The product was prepared by diazotized 4-amino benzoic acid coupled with resorcinol; Dark red color powder; Yield 92%; Rf 0.8; mp ( °C); 186-190, UV-vis (λ max, ethanol):394 nm; IR (KBr, γ, cm-1): 3412 (O-Hstr), 1601 (C=C str. resorcinol), 1478 (-N=N-),1685 (C=O str. of-COOH), 1240 (O-H bend), 1116 (C-O str.), 835 (1,4-CHAr); 1H NMR (DMSO-d6, δ ppm, 300 MHz): 10.05 (s, 1H, OH),13.73 (s, 1H, COOH), 6.75 (s, 1H, resorcinol H-2), 7.70 (d, 1H, resorcinol H-5), 6.55 (d, 1H, resorcinol H-6), 8.25-8.45 (dd, 4H, ArH); LC-MS (ret. time, % area); 1.841, 100; m/z; 259.1 (M+1); Analysis for C13H10N2O4: calcd % C, 60.47; H, 3.90; N, 10.85; Found %: C, 60.45; H, 3.87; N, 10.83.
4-(o-tolyldiazenyl) benzene-1, 3-diol, (4d)
The product was prepared by diazotized 2-toluidine and coupled with resorcinol; Dark red color powder, Yield 90%; Rf 0.8; mp.(°C); 178-180, UV-vis (λ max, ethanol):389 nm; IR (KBr, γ, cm-1): 3433 (O-Hstr), 1631 (C=C str. resorcinol), 1463 (-N=N-), 1242 (O-H bend), 1101 (C-O str.), 760 (1,2-CHAr); 1H NMR (DMSO-d6, δ ppm, 300 MHz): 10.87 (s, 1H, OH), 2.58 (s, 3H, CH3), 6.58 (s, 1H, resorcinol H-2), 7.78 (d, 1H, resorcinol H-5), 6.42 (d, 1H resorcinol H-6,), 7.31 (d, 1H, tolyl H-3'), 7.26 (m, 1H, tolyl H-4'), 7.76 (m, 1H, tolyl H-5'), 7.80 (d, 1H, tolyl H-6'); LC-MS (ret. time, % area); 2.358, 92.34; m/z; 229.01 (M+1); Analysis for C13H12N2O2: calcd % C, 68.41; H, 5.30; N, 12.27; Found %: C, 68.38; H, 5.29; N, 12.24.
4-((2, 4-dihydroxyphenyl) diazenyl)-1, 5-dimethyl-2-phenyl-1H-pyrazol-3(2H)-one (4e)
The product was prepared by diazotized 4-amino antipyrine coupled with resorcinol; Gray color powder, Yield 70%, Rf 0.7; mp ( °C); 217-220 UV-vis (λ max, ethanol):420 nm; IR (KBr, γ, cm-1): 3173 (O-Hstr.), 1604 (C=C str. resorcinol) 1687 (C=O str. pyrazolone), 1493 (-N=N-), 1258 (O-H bend), 1050 (C-O str.),1024 (C-N str.); 1H NMR (DMSO-d6, δ ppm, 300 MHz): 10.14 (s, 1H, OH), 3.39 (s, 3H, N-CH3), 2.49 (s, 3H, =C-CH3), 6.43 (s, 1H, resorcinol H-2), 7.37 (d, 1H, resorcinol H-5,), 6.40 (d, 1H, resorcinol H-6), 7.41-7.59 (m, 5H, ArH); LC-MS (ret. time, % area); 1.740, 51.83; m/z; 325.2 (M+1); Analysis for C17H16N4O3:calcd % C, 62.95; H, 4.97; N, 17.27; Found %: C, 62.97; H, 4.95; N, 17.25.
4-((2, 4-dihydroxyphenyl) diazenyl)-N-(5-methylisoxazol-3-yl) benzene sulfonamide (4f)
The product was prepared by diazotized sulfamethoxazole and coupled with resorcinol; Gray color powder, Yield 70%; Rf 0.7; mp ( °C); 226-230, UV-vis (λ max, ethanol):407 nm; IR (KBr, γ, cm-1): 3419, 3163 (O-H/NH str.), 1619 (C=C str.),1473 (-N=N-), 1320, 1149 (SO2 str. SO2NH), 994 (S-N str.),1024 (C-N str.); 1H NMR (DMSO-d6, δ ppm, 300 MHz): 6.15 (s, 1H, isoxazolyl H-4), 2.42(s, 3H, CH3), 12.01 (s, 1H, SO2 NH), 10.25 (s, 1H, OH), 6.42 (s, 1H, resorcinol H-2), 7.35(d, 1H, resorcinol H-5), 6.41 (d, 1H, resorcinol H-6), 7.95-8.45 (dd, 4H, ArH); LC-MS (ret. time, % area); 1.940, 91.83; m/z; 375.07 (M+1); Analysis for C16H14N4O5S: calcd % C, 51.33; H, 3.77; N, 14.97; S, 8.57; Found %: C, 51.32; H, 3.76; N, 14.98; S, 8.59.
Microbiological evaluation
In vitro antimicrobial activity
The above newly synthesized Benzene-1, 3-diol analogues were investigated over different microbial (baterial and fungal) strains viz. Acinetobacter baumannii (MTCC 1425), Escherichia coli (MTCC 614), Shigella flexneri (MTCC 1457), Pseudomonas aeruginosa (MTCC 1035), Klebsiella pneumoniae (MTCC 109), Bacillus circulans (MTCC 490), Staphylococcus mutans (MTCC 497),, Aspergillus niger (MTCC 9933) and Candida albicans (MTCC 3017) were procured from the Institute of Microbial Technology and Gene bank (IMTECH), Chandigarh, India. Candida glabrata, Cryptococcus neoformans and Trychophyton rubrum, Staphylococcus aureus and Bacillus subtilis strain hswx88 [18] were gifted by Pharmaceutical Biotechnology Division of the University Department of Pharmaceutical Sciences, Utkal University, Bhubaneswar, Odisha, India included for antimicrobial evaluation. Standard drugs Ampicillin and Fluconazole used as reference antibiotics (RA) against bacterial and fungal strains respectively.
Sterile petriplates were selected for performing antimicrobial sensitivity test of the said synthesized compounds (4a-4f). Each plate was filled with sterile molten nutrient agar for antibacterial activity and Sabouraud dextrose agar medium for antifungal activity with appropriate volume [9]. After solidification, 100 µl of inoculums were evenly distributed. Cups of 6 mm diameter were made using a sterile cork borer. Stock solution of above synthesized compounds and reference antibiotics was made using DMF at a concentration level of 1µgµl-1. The cups were filled with a definite volume and incubated 24 h for bacterial strains and 72 h for fungal strains at 37 °C. The diameter of the zone of inhibition was measured using the Hi-Antibiotic Zone scale (Hi-Media).
Determination of minimum inhibitory concentration (MIC)
The lowest concentration of the antimicrobial agents those inhibit the growth of the test organisms. 1 mgml-1 stock solution of synthesized compounds as well as reference compound was prepared using 10 % DMF solution (distilled water). Further different concentrations (500-31.25 µg/ml) were prepared by two fold serial dilution method. Agar well diffusion method and serial dilution assay procedure was employed to establish minimum inhibitory concentration. The different concentrations for respective compounds were loaded into the respective wells, and incubated at 37 °C for 18-24 h. After incubation MIC was determined [19].
Assay of antioxidant activity
The free radical scavenging activity of novel Benzene-1, 3-diol analogues (4a-4e) was measured by DPPH method with some modification [9]. The reaction mixture of synthesized compounds at different concentration aliquots was taken and the volume was adjusted up to 3 ml with methanol. To this mixture, 1 ml of 0.1 mM solution of DPPH in methanol was added. The mixture was kept in dark for 30 min for completion of reaction. The synthesized compounds exhibited free radical scavenging ability in comparison to standard Butylated hydroxy toluene (BHT). Optical density was measured at 517 nm and the % of inhibition concentration was calculated.
% of inhibition= [(Acont-Atest)/Acont] ×100
1 ml of 0.1 mM of methanolic solution of DPPH and 3 ml of methanol was considered as control.
Where Acont is the absorbance of control and Atest is the absorbance of the test. The sample concentration providing 50% inhibition (IC50) was measured by plotting inhibition percentages against concentration. All the experiments were carried out in triplicates and IC50 values were expressed as mean±SD.
Statistical analysis
The observed data on zone of inhibition for different synthesized compounds on different microbial strains were subjected to one way-analysis of variance (ANOVA) for comparison of mean. The mean zone of inhibition for each compound on each strain was compared with the reference compound (RA) through Dunnett Post Hoc test. The test of significance was done at 5% level of type one error. The null hypothesis was the zone of inhibition for test compound was higher than the reference compound.
Sample size determination
The minimum sample size determination was done for one way-analysis of variance with the help of the on line software https://www. statsdodo. com/SSizAOV_Pgm. php under the guidance of a statistician. A minimum sample size of five was calculated taking the probability of type 1 error (d) = 0.05, Power (1-β) =0.8, Number of groups 13 within group SD=2. However, a sample size of six has been taken in the study for each compound against each strain.
RESULTS AND DISCUSSION
Chemistry
Spectral analysis
The IR spectra of the entire compounds (4a-4f) shows board absorption band at 3450-3412 cm-1 due to stretching vibration of phenolic hydroxyl group except 4e at 3173 cm-1, the broadness is due to intramolecular hydrogen bonding between phenolic OH group and the azo groups. The strong two absorption bands at 1320 and 1149 cm-1 were assigned to sulfonyl stretching of sulfonamide group in compound 4f. The intense band at 1631-1601 cm-1 for all the compound was assigned to the C=C stretching of benzene-1, 3-diol. The absorption bands at 1685 and 1687 cm-1were indicated to the carbonyl stretching of carboxylic acid and pyrazolone derived compounds 4c and 4e respectively [20]. The medium absorption band at 1506-1463 cm-1 which attribute to-N=N-stretching frequency in all the synthesized compounds. The 1H NMR spectra shows board singlet peak at δ 10.05-10.87 ppm was due to presence the proton of the OH group in all the compounds. The three aromatic protons of the resorcinol ring in all the compounds except 4a, showed doublet and singlet peaks at a range of δ 6.40-7.78 and δ 6.42-6.75 ppm respectively. In the compound 4e 1H NMR spectra shows two sharp singlet peaks at δ3.39 and 2.49 ppm, which are assigned to N-CH3 and =C-CH3 groups respectively [20]. In addition to that one more singlet sharp peak at δ6.43 ppm, which indicates the proton of the aromatic resorcinol.
In the compound, 4f the 1H NMR spectra shows two singlet peaks at δ 2.42 and 6.15 ppm, which attribute to the proton of-C-CH3 and isoxazol H-4 respectively. The predicted molecular weight of synthesized compounds was confirmed by LC-MS. All the compounds were having their molecular ion peaks strongly reveal the predicted molecular formula.
Solvatochromic effect on different Benzene-1, 3-diol congeners
The solvent effects of the products were studied on UV-Visible spectrophotometer. The absorption spectra of these dyes (4a-4f) in different solvents at a concentration of 10-5 to 10-6 M, were reported in table 1.

Fig. 1: Solvatochromic effect of Benzene-1, 3-diol analogues in DMF
Table 1: Electronic absorption spectral data (λ max) nm of newly synthesized Benzene-1, 3-diol analogues (4a-4f)
| Comp. | λmax (Methanol) |
λmax Ethanol) |
λmax (2-propanol) |
λmax (DMSO) |
λmax (DMF) |
λmax (Chloroform) |
λmax (G. a. acid) |
λmax (0.1 N NaOH) |
λmax (0.1N HCl) |
| 4a | 391 | 392 | 391 | 395 | 424 | 388 | 390 | 475 | 383 |
| 4b | 384 | 386 | 387 | 391 | 391 | - | 383 | 481 | 380 |
| 4c | 393 | 394 | 398 | 405 | 423 | - | 398 | 474 | 391 |
| 4d | 387 | 389 | 388 | 390 | 427 | 383 | 385 | 444 | 381 |
| 4e | 380 | 380, 420 | 382 | 397, 428 | 394, 425 | - | 495 | 462 | 488 |
| 4f | 254, 405 | 254, 407 | 256, 406 | 263, 408 | 268, 415 | 257, 425 | 258,401 | 243, 497 | 283, 453 |
The synthesized compound 4e shows bathochromic shift in Dimethyl formamide and Dimethyl sulphoxide with respect to the λ max in comparison to other polar solvents. In addition to these a good bathochromic shift also found to be observed by compound 4e in acidic and alkaline solutions. The resulting bathochromic shift by the compound 4e than other resorcinol congeners may be due to the existence of 4-(2-phenyl, 1, 5 dimethyl 3-oxo) pyrazolyl substituent at the C-5 position. There is no appreciable change in λmax of compound 4f in all protic solvents, whereas a slight difference was observed in chloroform and a major shift occured in 0.1N HCl and 0.1N NaOH at 453 and 497 nm respectively. The heteroaryl substituents (pyrazolone, isoxazole) moiety in resorcinol may responsible for the largest bathochromic shift in comparison to other resorcinol congeners. The solvatochromic behavior of all the newly synthesized resorcinol analogues in DMF is mentioned in fig. 1.
Thermal analysis
The DSC thermogram reported sharp and narrow endothermic peak by compound 4d showed peak temperature at 178.50 °C corresponding to its melting point (fig. 2).

Fig. 2: DSC Thermogram of compound 4d
Microbiology
Antimicrobial activity
Most of the synthesized Benzene,-1,3-diol congeners having effective antimicrobial activity. The mean±SD of the zone of inhibition for each microbial strain has been compared by one way-analysis of variance and the resulting p value. The mean zone of inhibition among the different compounds was found to be significantly different with p value of 0.00.
The highest mean zone of inhibitions observed by compound 4e against S. mutans, B. circulans, S. flexneri, P. aeruginosa and B. subtilis are (31.33±2.34), (28.17±1.6), (24±1.79), (26.83±2.86) and (26.83±2.04) respectively and by compound 4b against E. coli and K. pneumonia are (26.5±2.51) and (29±1.27) respectively. A. baumannii and S. aureus is observed with highest mean zone of inhibitions (26.17±2.86) and (27.83±1.84) by compound 4c and 4f respectively.
The pair wise comparison of each of the newly synthesized compounds with the standard is expressed in mean difference±SEM, revealed that 4b is significant in comparison RA (p<0.05) against K. pneumonia, whereas compound 4c is significant in comparison to RA against E. coli, S. flexneri, P. aeruginosa, K. pneumonia, B. subtilis and S. aureus. The bacterial strains S. mutans, S. flexneri, P. aeruginosa B. subtilis and B. circulans showed significant zone of inhibition by compound 4e in comparison to RA. Compound 4f showed significant zone of inhibition in comparison to RA against E. coli, S. flexneri, B. circulans and S. aureus (table 2).
Table 2: Zone of Inhibition (mm) of newly synthesized Benzene-1, 3-diol analogues (4a-4f) against bacterial strains
| Comp. | A. baumannii | E. coli | S. flexneri | P. aeruginosa | K. pnumonia | B. subtilis | B. circulans | S. mutans | S. aureus |
| 4a | -11.5±1.4 | -5.33±1.12 | -3.67±0.92 | -5.67±1.05 | -3.17±1.07 | -2.17±1.49 | - | -15±1.17 | -8.5±1.04 |
| 4b | -7±1.4 | 1.33±1.12 | -6.5±0.92 | 1.67±1.05 | 8.17±1.07* | - | -1±1.22 | 1.17±1.17 | 0.33±1.04 |
| 4c | -2.5±1.4 | 4.17±1.12* | 2.33±0.92* | 5±1.05* | 5.83±1.07* | 4.33±1.49* | -5±1.22 | -1.33±1.17 | 4.67±1.04* |
| 4d | -12±1.4 | -8.83±1.12 | -6.17±0.92 | -4.33±1.05 | -7.33±1.07 | -3±1.49 | -4±1.22 | -15.33±1.17 | -6.67±1.04 |
| 4e | -6.33±1.4 | 1.67±1.12 | 3.67±0.92* | 6.17±1.05* | -3±1.07 | 7.17±1.49* | 4.33±1.22* | 3.33±1.17* | 2±1.04 |
| 4f | -9.33±1.4 | 3.83±1.12* | 2.67±0.92* | 2.33±1.05 | 1.5±1.07 | -3.83±1.49 | 3.33±1.22* | 1.5±1.17 | 5.83±1.04* |
Results were expressed in (mean±SEM, n=6) followed by Dunnett Post Hoc test followed by One way ANOVA. (Statistical significance at *p<0.05 in comparison to RA).
No zone of inhibition
S. mutans-Staphylococcus mutans (MTCC 497), B. circulans-Bacillus circulans (MTCC 490), S. flexneri-Shigella flexneri (MTCC 1457), E. coli-Escherichia coli (MTCC 614), P. aeruginosa-Pseudomonas aeruginosa (MTCC 1035), K. pneumoniae-Klebsiella pneumoniae (MTCC 109), B. subtilis-Bacillus subtilis, A. baumannii-Acinetobacter baumannii (MTCC 1425), S. aureus-Staphylococcus aureus.
The highest mean zone of inhibitions for antifungal activity observed by compound 4e against A. niger and T. rubrum is (23.67±1.63) and (19.33±1.97) respectively and by compound 4b against C. albicans and C. neoformans is (29.17±1.33) and (31.33±2.34) respectively. C. glabrata is found to be observed with the highest mean zone of inhibition (21.17±0.98) by compound 4f.
The pair wise comparison of each of the newly synthesized compounds with the standard is expressed in mean difference±SEM, revealed that 4b is significant in comparison to RA (p<0.05) against C. albicans and C. neoformans whereas compound 4c is significant in comparison to RA against A. niger and compound 4e is significant in comparison to RA against A. niger, T. rubrum and C. glabrata. Compound 4f is significant in comparison to RA against A. niger, C. glabrata and C. neoformans (table 3).
Table 3: Zone of Inhibition (mm) of newly synthesized Benzene-1, 3-diol analogues (4a-4f) against various fungal strains
| Comp | A. niger | T. rubrum | C. albicans | C. glabrata | C. neoformans |
| 4a | 2±1.01 | -1.5±0.82 | -7.33±1.02 | -6±0.78 | -7.17±0.99 |
| 4b | 0.17±1.01 | -1.5±0.82 | 3.17±1.02* | -4.17±0.78 | 3.67±0.99* |
| 4c | 2.67±1.01* | -1.5±0.82 | -7.5±1.02 | -6.17±0.78 | -0.67±0.99 |
| 4d | 0.5±1.01 | -1.83±0.82 | -5.33±1.02 | -6.17±0.78 | -2.5±0.99 |
| 4e | 4.67±1.01* | 2.67±0.82* | -7.5±1.02 | 2.17±0.78* | 1.17±0.99 |
| 4f | 4±1.01* | 1.5±0.82 | -14.17±1.02 | 2.17±0.78* | 2.67±0.99* |
Results were expressed in (mean±SEM, n=6) followed by Dunnett Post Hoc test followed by One way ANOVA. (Statistical significance at *p<0.05 in comparison to RA), A. niger-Aspergillus niger (MTCC 9933), C. albicans-Candida albicans (MTCC 3017), C. glabrata-Candida glabrata, C. neoformans-Cryptococcus neoformans, T. rubrum-Trychophyton rubrum
The synthesized azo-resorcinol analogues exhibited broad spectrum antibacterial activity against different bacterial pathogens, most of which are causing urinary tract infections [21]. Compound 4c and 4f was observed with significant antibacterial activity against E. coli which is a leading organism causing UTIs. The antifungal effect of compounds 4a-4e against C. neoformans and C. albicans are mentioned in fig. 3.
Fig. 3: The antifungal effect of compounds 4a-4e against C. neoformans and C. albicans in plate (A) and (B) respectively
The significant antimicrobial activity of compound 4c and 4e in was graphically interpreted with the help of error bars in fig. 4.

Fig. 4: Graphical interpretation for significant antimicrobial effect of Benzene-1, 3-diol analogue 4c and 4e respectively
Table 4: Minimum inhibitory concentration (µg/ml) values of newly synthesized Benzene-1, 3-diol analogues (4a-4f) against various bacterial strains
| Compd. | A. baumannii | E. coli | S. flexneri | P. aeruginosa | K. pneumonia | B. circulans | B. subtilis | S. mutans | S. aureus |
| 4a | 125 | 125 | 125 | 125 | 500 | - | 250 | 62.5 | 62.5 |
| 4b | 31.25 | 31.25 | 125 | 31.25 | 31.25 | 31.25 | - | 31.25 | 31.25 |
| 4c | 31.25 | 31.25 | 31.25 | 31.25 | 62.5 | 31.25 | 31.25 | 31.25 | 31.25 |
| 4d | 125 | 62.5 | 125 | 125 | 125 | 31.25 | 125 | 62.5 | 62.5 |
| 4e | 31.25 | 31.25 | 31.25 | 31.25 | 31.25 | 31.25 | 31.25 | 31.25 | 31.25 |
| 4f | 125 | 125 | 31.25 | 31.25 | 31.25 | 31.25 | 31.25 | 31.25 | 31.25 |
| RA | 31.25 | 31.25 | 31.25 | 31.25 | 31.25 | 31.25 | 31.25 | 31.25 | 31.25 |
MIC-Minimum Inhibitory Concentration
Evaluation of minimum inhibitory concentrations
The inhibitory property of the Benzene-1, 3-diol analogues was determined in terms of MIC (µg/ml). The MIC values of the test analogues against different bacterial strains were investigated to determine the minimum level of concentration at which the compound is able to exert its activity (table 4).
No zone of inhibition
A. baumannii-Acinetobacter baumannii,, B. circulans-Bacillus circulans, S. flexneri-Shigella flexneri, E. coli-Escherichia coli, P. aeruginosa-Pseudomonas aeruginosa, K. pneumoniae-Klebsiella pneumoniae, S. mutans-Staphylococcus mutans, B. subtilis-Bacillus subtilis,, S. aureus-Staphylococcus aureus.
All the Benzene-1, 3-diol analogues exhibited potential antibacterial activity by inhibiting the growth of different bacterial strains among which the Benzene-1, 3-diol hetero aryl analogue 4e can inhibit the growth of all the nine pathogens at a concentration level of 31.25 µg/ml. The 4-carboxy phenyl substituted benzene-1,3-diol analogue 4c is the next to highest potent compound which can inhibit the growth of eight bacterial pathogens at a concentration of 31.25 µg/ml. Compound 4f exhibited its activity against seven different organisms at a minimum inhibitory concentration level 31.25 µg/ml. The reference antibiotic (Ampicillin) can able to exhibit its MIC against all the bacterial strains at 31.25 µg/ml. The antibacterial activity is exhibited by all the compounds except 4a against B. circulans at a MIC level of 31.25µg/ml.
In vitro antioxidant screening
DPPH method has earned a reputation for the evaluation of anti-radical activity of synthesized compounds. Donating of hydrogen atom or an electron by the test compounds to DPPH may be the mechanism of anti-oxidation. DPPH radicals accept the hydrogen atom or an electron from the organic molecules and can form stable dimagnetic molecules. Scavenging effect of newly synthesized compounds 4a, 4b, 4c, 4d and 4e showed potential antioxidant activity and all the test compounds reported with 50 % of inhibition (IC50) at a concentration level of (42±1.13, 38±1.4, 40±0.59, 56±0.78 and 48±0.89) µg/ml respectively whereas, the standard BHT at 32±0.80 µg/ml. The DPPH radical scavenging effects of Benzene-1, 3-diol analogues with standard Butylated hydroxy toluene (BHT) and the error bars at respective concentrations are given in fig. 5.

Fig. 5: DPPH radical scavenging effects of Benzene-1, 3-diol analogues with standard Butylated hydroxy toluene (BHT)
The compound 4b and 4c showed better anti-oxidant activity than the compounds 4a and 4e. The study revealed that the presence of pyrazolone nucleus and the increased positive charge on the phenolic hydroxyl group of resorcinol associated with negative inductive effect of these groups in compound 4e may be responsible for enhancing of its antioxidant activity. The positive charge intensification may leads to free radical inhibition. Polyhydroxy substituted compound, 4b may be responsible for its highest antioxidant activity. In comparison to all the newly synthesized compounds 4b exhibited 50% inhibition at the lowest concentration level of 38±1.4 µg/ml (table 5).
Table 5: Antioxidant activity of newly synthesized Benzene-1, 3-diol analogues (4a-4e)
| Conc. µg/ml | |||||
| 10 | 30 | 50 | 70 | IC50 | |
| Compound | % Inhibition | (µg/ml) | |||
| 4a | 23.53±0.04 | 41.41±0.07 | 57.71±0.07 | 91.11±0.04 | 42±1.13 |
| 4b | 36.53±0.02 | 43.03±0.04 | 61.97±0.08 | 73.78±0.07 | 38±1.4 |
| 4c | 25.43±0.08 | 39.65±0.09 | 61.41±0.04 | 83.11±0.04 | 40±0.59 |
| 4d | 27.99±0.04 | 39.34±0.02 | 49.09±0.07 | 63.9±0.05 | 56±0.78 |
| 4e | 28.43±0.07 | 41.83±0.02 | 51.41±0.05 | 79.97±0.06 | 48±0.89 |
| BHT | 32.33±0.01 | 49.53±0.02 | 59.98±0.09 | 77.99±0.07 | 32±0.80 |
The results were expressed in the form of (mean±SD, n=3), BHT-Butylated Hydroxy Toluene.
Table 6: Antioxidant activity of newly synthesized Benzene-1, 3-diol analogues (4a-4e)
| Conc. µg/ml | ||||
| Compound | 10 | 30 | 50 | 70 |
| % Inhibition | ||||
| I | J | Mean difference (I-J) | p | Mean difference (I-J) |
| 4a | BHT | -8.80±0.04 | 1 | -8.12±0.04 |
| 4b | BHT | 4.20±0.04* | 0 | -6.50±0.04 |
| 4c | BHT | -6.90±0.04 | 1 | -9.88±0.04 |
| 4d | BHT | -4.34±0.04 | 1 | -10.19±0.04 |
| 4e | BHT | -3.90±0.04 | 1 | -7.70±0.04 |
The results were expressed in the form of (mean difference±SEM, n=3), BHT-Butylated Hydroxy Toluene.
Literature survey reveals that Cloxacillin is highly resistant to Staphylococcus aureus. The resorcinol based newly synthesized azo compounds 4-((2, 4-dihydroxyphenyl) diazenyl) benzoic acid, 4-((2, 4-dihydroxyphenyl) diazenyl)-1, 5-dimethyl-2-phenyl-1H-pyrazol-3(2H)-one and 4-((2, 4-dihydroxyphenyl) diazenyl)-N-(5-methylisoxazol-3-yl) benzene sulfonamide were observed with significant antimicrobial activity against S. aureus which may be a new light for the treatment of bacterial resistance diseases caused by S. aureus. Among various pathogenic bacterial strains, E. coli is the leading organism responsible for urinary tract infections. The antimicrobial results revealed that azo-based resorcinol congeners are significantly effective against E. coli. Resorcinol congeners bearing phenolic OH substituent and pyrazolone are equally important for the antioxidant activity, which is reflected clearly in this research. Literature survey also revealed that the heterocyclic functionalities are responsible for the antioxidant ability of the compound. In further investigations, these ligands can be used for new azo transitional metal complex.
CONCLUSION
The novel synthesized benzene-1, 3-diol analogues were structurally interpreted by spectral characterization and the composition was confirmed by LC-MS. All the synthesized benzene-1, 3-diol derivatives were subjected to biological evaluation. The compounds 4c, 4e and 4f showed significant antibacterial activity against different bacterial strains whereas, compounds 4c and 4e showed significant antifungal activity against A. niger. Only compound, 4b showed significant antifungal activity against C. albicans. The 4-amino phenol and 4-amino benzoic acid conjugated azobenzene-1, 3-diol derivatives 4b and 4c showed good antioxidant activity and the IC50of the said compounds even showed at a concentration of 38±1.4 and 40±0.59 (µg/ml). This recent study justified the aim and objective of the research and definitely paves new ways to design and synthesize new azobenzene-1, 3-diol molecules and to explore their biological activities for future researchers.
ACKNOWLEDGEMENT
The authors indebtly acknowledge the Dean, School of Pharmaceutical Sciences, Siksha ‘O’ Anusandhan University, Director of NISER, IMMT and Deputy Director RIAES, Bhubaneswar, India. Sincere thanks to Lecturer in English, IHSE, S’O’A University for his kind cooperation in proof-reading the manuscript.
CONFLICT OF INTERESTS
The authors have no conflict.
REFERENCES
- El-Dossoki FI, Seify El. Physicochemical studies on 4-(4′-Phenyl-2′-thiazolylazo) Resorcinol and Its complexation with some metal Ions. J Chem Eng Data 2010;55(9):3572-7.
- Awale AG, Gholse SB, Utale PS. Synthesis, spectral properties and applications of some mordant and disperse mono azo dyes derived from 2-amino-1, 3-benzothiazole. Res J Chem Sci 2013;3(10):81-7.
- Eigenmann PA, Haengelli CA. Food colourings and preservatives-allergy and hyperactivity. Lancet 2004;364(9437):823-4.
- Marchevsky E, Olsina R, Marone C. 2-[2-(5-Chloropyridyll) azo]-5-dimethylaminophenol as indicator for the complexometric determination of zinc. Talanta 1985;32(1):54-6.
- Syed MA, Sim HC, Khalid A, Shukor M. A simple method to screen for azo-dye-degrading bacteria. J Environ Biol 2009;30(1):89-92.
- Knop A, Scheib W. Chemistry and application of phenolic resins. Verlag: Springer; 1979.
- Jignesh HP, Rajendra NJ, Kalpesh JG. Spectral characterization and biological evaluation of schiff bases and their mixed ligand metal complexes derived from 4, 6-diacetylresorcinol. J Saudi Chem Soc 2014;18:190-9.
- Chinnagiri T, Keerthi K, Keshavayya J, Tantry NR, Sanehalli KP, Angadi RSA. Characterization and biological activity 0f 5-phenyl-1, 3, 4-thiadiazole-2-amine incorporated azo dye derivatives. Org Chem Int 2013;7:1-7.
- Shridhar AH, Keshavayya J, Peethambar SK, Peethambar SK, Hoskeri HJ. Synthesis and biological activities of Bis alkyl 1, 3, 4-oxadiazole incorporated azo dye derivatives. Arab J Chem 2012. doi.org/10.1016/j. arabjc.2012.04.018. [Article in Press].
- Child RG, Wilkinson RG, Tomcu FA. Effect of substrate orientation of the adhesion of polymer joints. Chem Abstr 1977;87:6031.
- Sanjay FT, Dinesh MP, Manish PP, Ranjan GP. Synthesis and antibacterial activity of novel pyrazolol [3,4-b] quinoline based heterocyclic azo compounds and their dyeing performance. Saudi Pharm J 2007;15:48.
- Abdi AH, Eissa AA, Hassan GS. Synthesis of novel 1, 3, 4-trisubstituted pyrazole derivatives and their evaluation as antitumor and anti-angiogenic agents. Chem Pharm Bull 2003;51(7):838-44.
- Sahoo J, Sudhir Kumar P. Biological evaluation and spectral characterization of 4-hydroxy coumarin analogues. J Taibah University Med Sci 2015. doi.org/10.1016/j. jtumed.2015.03.001. [Article in Press].
- Metwally MA, Suleiman YA, Gouda MA, Harmal AN, Khalil AM. Synthesis, antitumor and antioxidant evaluation of some new antipyrine based azo dyes incorporating pyrazolone moiety. Int J Mod Org Chem 2012;1(3):213-5.
- Garg HG, Prakash CJ. Preparation of 4-arylazo-3, 5-disubstituted-(2H)-1,2,6-thiadiazine 1,1-dioxides. J Med Chem 1972;15(4):435-6.
- Prasanth NV, Muhas C, Jaffer CP. Antimicrobial resistance pattern among selected pathogenic bacterial strains from various departments of a tertiary level hospital in South Malbar region of Kerala. Indian J Hosp Pharm 2014;51:103-8.
- Sahoo J, Mekap SK, Sudhir Kumar P. Synthesis, spectral characterization of some new 3-Heteroaryl azo 4-Hydroxy coumarin derivatives and their antimicrobial evaluation. J Taibah Univ Sci 2015;9:187-95.
- Pradhan B, Dash SK, Sahoo S. Screening and characterization of extracelluar L-asparaginase producing bacillus subtilis strain hswx88, isolated from taptapani hotspring of odisha, India. Asian Pac J Trop Biomed 2013;3(12):936-41.
- Khabnadideh S, Rezaei Z, Ghasemi Y, Montazeri-Najafabady N. Antibacterial activity of some new azole compounds. Anti-Infect Agents 2012; 10:26-33.
- Ajay S, Ran C, Byunghun C, Joonseok K. Synthesis and properties of some novel pyrazolone-based heterocyclic azo disperse dyes containing a fluorosulfonyl group. Dyes Pigm 2012;9:580-6.
- Sahu L, Jena S, Swain SS, Sahoo S, Chand PK. Agrobacterium rhizogenes-mediated transformation of a multi-medicinal herb, Boerhaavia diffusa L.: optimization of the process and anti-microbial activity against bacterial pathogens causing urinary tract infections. Front Life Sci 2014;7(3-4):197-9.